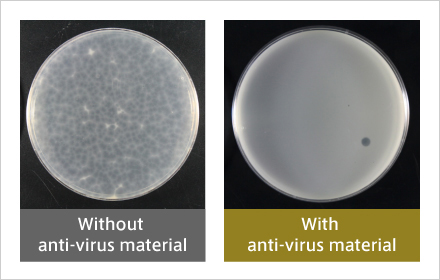
Antiviral activity against enveloped viruses similar to COVID19 (after 6 hours). Almost all plaques are found to have disappeared.
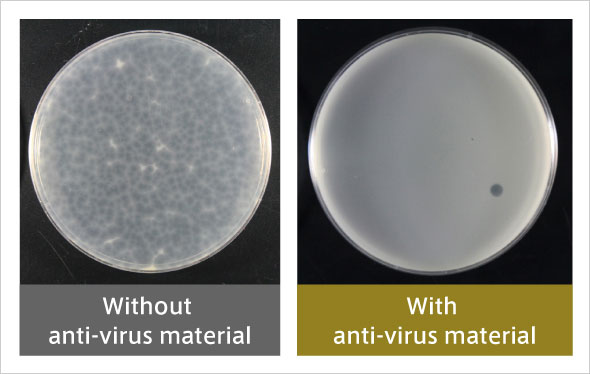
Antiviral activity against enveloped viruses similar to COVID19 (after 6 hours). Almost all plaques are found to have disappeared.

Research
Tokyo Institute of Technology merged with Tokyo Medical and Dental University to form Institute of Science Tokyo (Science Tokyo) on October 1, 2024.
Over time, content on this site will be migrated to the Science Tokyo Web. Any information published on this site will be valid in relation to Science Tokyo.

Research


The global spread of COVID-19 rages on, with no clear end in sight. Development work on vaccines and therapeutic agents is intense, led by pharmaceutical companies and medical universities. New technologies such as RNA vaccines* are also being tried. Expectations for science and technology to provide solutions continue to rise.
As a technical university, Tokyo Tech promotes collaboration between medicine and engineering, and it has conducted many studies on medical and public health applications from an engineering standpoint. Investigations have covered concepts related to infectious diseases, such as anti-viral materials, rapid and highly sensitive virus detection methods using antibodies, wearable blood flow imaging devices, electromagnetic ECMO (extracorporeal membrane oxygenation) components that lower the chance of blood clots, and AI drug discovery using the supercomputer TSUBAME.
This feature introduces these five studies and their impact on the future of medicine and public health, while also sending a message from each scientist to the young researchers and students who will one day take up the torch.
*RNA vaccine: Conventional vaccines use an inactivated pathogen or some of the pathogen's proteins to induce an immune response. In contrast, RNA vaccines and DNA vaccines function by administering genes to create proteins in the body, causing an immune response.
Akira Nakajima, Professor, School of Materials and Chemical Technology

Structure of α-La2Mo2O9, New material: LMO
I. Evans, Chem. Mater., 17, 4074 (2005)
Originally, we were conducting research on inorganic functional materials connected to environmental cleanup and energy conservation. At the time, we were aiming to develop photocatalysts that purify and remove hazardous materials, as well as water repellent materials that inhibit interaction with water. About three years ago, in the process of researching photocatalysts, we learned that molybdenum oxide (MoO3) has excellent antibacterial activity. MoO3 tends to dissolve in water and lose its activity immediately. But when we produced a composite oxide (La2Mo2O9, LMO) from the water-repellent rare earth lanthanum (La) oxide and MoO3, it exhibited not only water repellency but also very high antibacterial and antiviral activity. LMO is less expensive than the conventional inorganic antimicrobial material silver, and because it is an oxide, it does not deteriorate with age or stain due to corrosion. Unlike titanium oxide (TiO2), which is used as a photocatalyst, it has many advantages such as high activity even in the absence of light. Currently, in collaboration with the Kanagawa Institute of Industrial Science and Technology, we are working on development towards practical use.

Structure of α-La2Mo2O9, New material: LMO
I. Evans, Chem. Mater., 17, 4074 (2005)


Antiviral activity against enveloped viruses similar to COVID19 (after 6 hours).
Almost all plaques are found to have disappeared.
Initially, the LMO showed very high antiviral activity against a surrogate virus of norovirus, but not particularly high activity against a surrogate virus of influenza virus. The new coronavirus (SARS-CoV-2) is an enveloped virus similar to the influenza virus. In order to enhance the activity of the LMO, we conducted a study to replace some of the constituent elements with other elements. Last year, we succeeded in developing an LMO that exhibits extremely high antiviral activity against even an influenza surrogate virus.
With COVID-19, we have learned that until a vaccine is developed and disseminated, we must conscientiously adopt a new normal of wearing masks and social distancing, and hold out without stopping our economic and social activities. To that end, prevention and infection control technologies are as important as the development of therapeutic drugs and vaccines. Anti-virus materials like LMO will be one of our aces. Furthermore, we believe that this material will be effective at ensuring a sanitary environment in areas affected by large-scale natural disasters, which have been occurring more frequently in recent years.

Antiviral activity against enveloped viruses similar to COVID19 (after 6 hours). Almost all plaques are found to have disappeared.
The specific mechanism of LMO antiviral activity is not yet well understood. It has been reported that water repellency has a certain effect on antibacterial and antiviral activity. Therefore, we plan to clarify the mechanism both theoretically and experimentally. We have received inquiries from over 20 companies, and we plan to provide them with sample materials. For example, a coating material that incorporates LMO can likely be applied to wallpaper, smartphones, and straps in vehicles. I hope that within one and a half to two years, companies will commercialize the material, to the benefit of the world.
Message from Professor Akira Nakajima

Akira Nakajima,
Professor, School of Materials
and Chemical Technology
Message from Professor Akira Nakajima
Due to the global spread of COVID-19, the LMO we developed two years ago has come to the fore. However, originally we did not start research on LMOs with the motivation to save humankind or put it into practical use to make money. It was just intellectual curiosity. We're lucky that it might eventually be useful to the world. I hope that the young people who will lead our future world will value their intellectual curiosity. Especially with inorganic materials, there are still many unknowns. I will continue to enjoy doing research together with students in order to solve mysteries and discover the unknown.
Hiroshi Ueda, Professor, Laboratory for Chemistry and Life Science, Institute of Innovative Research
My expertise is in functional proteins (mainly antibodies). Simply put, I artificially modify proteins to make them easier for humans to use. When a pathogen such as a virus enters the body, the body recognizes the foreign substance as an antigen and produces antibodies to suppress or eliminate these targets. This immune function of the human body is called the antigen-antibody reaction. Antibodies have very high specificity for the molecules they recognize, and are also used as pharmaceuticals. We use these mechanisms of action to develop functional proteins.
To date, an antigen concentration measurement method (immunoassay) was developed that utilizes the antigen-antibody reaction. Since it can detect various types of pathogens, it has come to be recognized as a superior method for testing and diagnosis. However, there is demand for easier, faster, and more sensitive methods. To that end, my laboratory has developed a new fluorescent immunoassay reagent called "Q-body". Q-body is a fluorescent dye-labeled antibody molecule used for immunoassay. Normally, this fluorescent dye is "quenched", and it emits fluorescence only when it binds to an antigen. So the greatest feature is that it can be measured instantly with high sensitivity. The use of Q-body has made it possible to detect even a small amount of influenza virus. It can be detected simply by mixing Q-body with a solution in which the antigen is dissolved, making it simple to run, fast, and low-cost.
Furthermore, together with Associate Professor Tetsuya Kitaguchi, our laboratory is developing the biosensor "Flashbody" that emits light when an antigen binds to it. This is a fluorescent protein bound to an antibody, and when a virus or other antigen comes inside the cell, it can even be observed using a fluorescence microscope.


Q-body: ● An antibody whose fluorescence is enhanced by antigen binding,
● The antigen can be detected with high sensitivity by mixing with the sample.
R. Abe, et al. J. Am. Chem. Soc. 133, 17386-17394 (2011). [10.1021/ja205925j]![]()
Although the principles of Q-body and Flashbody are slightly different, they are characterized by their strong affinity to bind a variety of target antigens. For example, in order to detect the new coronavirus (SARS-CoV-2) with high accuracy using Q-body, it will be important to find the optimal antibody. Antibody candidates have been put forward, and we are currently investigating their performance. Increasing sensitivity and lowering costs are further challenges. There is a limit to the affinity of one antibody to bind to antigens, so we plan to link multiple antibodies to increase binding capacity and raise sensitivity.
In the United States, a mask is being developed that emits fluorescence when a virus sticks to it, and we also want to make something like this. I think it would be useful if we could actually see the virus with our own eyes.


Anti-Influenza H1N1 Q body: HA antigens at nM level could be detected fluorescently just by mixing with samples.
H.J. Jeong , J. Dong and H. Ueda "Single step detection of influenza virushemagglutinin using bacterially produced Quenchbodies" Sensors 19, 52 (2019). [1424-8220/19/1/52]![]()
We are looking for partner companies to commercialize Q-body and Flashbody. We aim to commercialize them as soon as possible. COVID-19 has not yet reached its end, and concerns of spreading infection persist all over the world, so there is urgent need for both diagnosis and treatment solutions. Under these circumstances, we would like to help in ensuring people's health and safety in and after the COVID-19 era by developing a simple and inexpensive immunoassay such as Q-body.
Message from Professor Hiroshi Ueda

Hiroshi Ueda, Professor,
Laboratory for Chemistry
and Life Science,
Institute of Innovative Research
Message from Professor Hiroshi Ueda
I myself specialize in chemical engineering. When I was a student, there was a biotechnology boom, and the professor of my lab began to focus on protein engineering, so I also committed myself to this area. In particular, I became interested in antigen-antibody reaction and studied abroad at a lab at the University of Cambridge to learn about the production of humanized antibodies. However, it wasn't that I was keen on one day developing pharmaceuticals to benefit the world. The research was simply fun. Even with the current spread of COVID-19, we are focusing on the Q-body, which emits fluorescence when the antigen binds to it, a phenomenon we discovered by chance and not by design. What I want to convey to young people from these experiences is to value what you find interesting. Whether or not the research will be useful to the world is something no one knows.
Hiroaki Iino, Associate Professor, Laboratory for Future Interdisciplinary Research of Science and Technology, Institute of Innovative Research
My expertise is in "organic electronics", making semiconductor devices using organic materials. Unlike conventional semiconductor devices made with inorganic materials, organic semiconductor devices are manufactured using printing technology at room temperature, making them low energy and low cost. Fabricating organic semiconductor devices on flexible and lightweight plastic substrates could allow for applications in wearable devices. They also hold promise in disposable sensor devices geared towards IoT.
What makes my research unique is the use of liquid crystalline materials. Liquid crystals are substances that have intermediate properties, between a solid and a liquid. And liquid crystal displays are one application that utilizes these properties. Normally, it is very difficult to make a quality crystalline thin film with an organic material, but in the case of a liquid crystal organic material, you can easily make a quality crystalline thin film simply by dissolving it in a solution, applying it to the substrate, and drying it. The reason is that the molecules of the liquid crystalline materials are regularly arranged in a self-organizing manner. If the crystalline thin film is flat and dense, electrons can move through it at a high speed, which improves its performance as a semiconductor. Currently, we are focusing on development of thin film transistors and near-infrared photodiodes that use this organic material. By integrating these two, we aim to develop a near-infrared image sensor. An image sensor converts light into electrical signals. Our organic materials have the property of easily absorbing near-infrared rays. We did not previously consider medical applications, as we have been looking at a potential use in organic thin film solar cells. However, since near-infrared rays easily penetrate tissue, it is possible to photograph the inside of the body by attaching a near-infrared image sensor to the skin and shining near-infrared rays from outside. I heard that infection with COVID-19 makes blood clots more likely, and I thought that using a near-infrared image sensor could help with early detection by imaging blood vessels. So I've started to explore the idea.


LeftAbove: Chemical structure of self-organizing organic semiconductor material (Ph-BTBT-10) and its aggregated conformation, and structure of thin-film transistor
RightBelow: Thin-film transistors fabricated on a flexible substrate

Left: Chemical structure of self-organizing organic semiconductor material (8H2Pc) and structure of photo diode
Right: Photo diode fabricated on a flexible substrate

Chemical structure of self-organizing organic semiconductor material (8H2Pc) and structure of photo diode

Photo diode fabricated on a flexible substrate
Since I have no expertise in medicine, I plan to pursue the medical application of near-infrared image sensors in collaboration with Dr. Wataru Hijikata from the School of Engineering and Dr. Tadahiko Shinshi from the Institute of Innovative Research, who are studying ECMO blood pumps. In the case of infectious diseases such as COVID-19, semiconductor devices that come into direct contact with the human body must be inexpensive and disposable. In that respect, I think semiconductor devices made from organic materials are highly useful. However, further improvements in productivity and stability are essential for practical applications.
I have just begun studying the application of near-infrared image sensors in medicine, so it is unclear whether or not they will actually prove useful. But even if this amounts to just a small contribution, I will do whatever I can.
Message from Associate Professor Hiroaki Iino

Hiroaki Iino,
Associate Professor,
Laboratory for Future Interdisciplinary
Research of Science and Technology,
Institute of Innovative Research
Message from Associate Professor Hiroaki Iino
My expertise is in organic electronics. I have never been involved in medicine, so collaborating with people in medicine was an unexpected development. We will be testing whether my near-infrared image sensor would be useful in the medical field. I don't know what will happen, so it's a new endeavor for me. What I want to convey to young people through this experience is that at any given time, they should do their best to focus on what interests them. The culmination of your efforts can bring about unexpected developments. In fact, even in my lab, there are times during experiments when we find new phenomena that we did not anticipate. So I tell students to always cherish unexpected developments.
Wataru Hijikata, Associate Professor, School of Engineering
When COVID-19 causes severe viral pneumonia, it leads to respiratory distress. Normally a ventilator is used, but when patients have difficulty breathing with their own lungs, extracorporeal membrane oxygenation (ECMO) is used as a last resort. The ECMO sends the patient's blood to an artificial lung with a blood pump, removes carbon dioxide in the blood, supplies the blood with oxygen, and returns it to the body.

Maglev blood pump
We have been researching the blood pump component of ECMOs. A blood pump pumps blood by rotating a vane wheel called an impeller. In the case of a normal vane wheel, the bearings are lubricated to prevent wear due to rotation. But in the case of a blood pump, the impeller is completely immersed in blood, so it cannot be lubricated. This presents a problem of low durability. A further problem is that red blood cells are crushed and damaged by the impeller, making blood clots more likely. Under the guidance of Professor Tadahiko Shinshi at the Laboratory for Future Interdisciplinary Research of Science and Technology, we developed a blood pump that solves these problems by using electromagnetic force to levitate and rotate the impeller. Our blood pump is now undergoing tests for clinical application.

Maglev blood pump
Studies have shown that COVID-19 patients are more likely to develop blood clots. A blood clot increases the risk of a cerebral or myocardial infarction. What this means for ECMO is that, more than ever, there is strong demand for the development of blood pumps that are less likely to cause blood clots; and development of impellers with materials and shapes less likely to cause blood clots are underway around the world. We have focused on the fact that blood adheres to the surface of the impeller, making blood clots more likely. My idea was to apply high-frequency vibrations to the impeller, which is levitated using electromagnetic force, making blood clots less likely to adhere to the surface of the impeller. Through experiments, it was confirmed that adherence of blood clots was dramatically reduced when the impeller was vibrating, compared with when the impeller was not.


Magnetically Levitated blood pump for ECMO
Currently, I am collaborating with Tokyo Medical and Dental University and Asahikawa Medical University on bringing a blood pump equipped with this impeller to practical application. The advantage of this technology is that it can be applied to existing ECMOs simply by changing a program. With the current situation so dire, we hope to complete our testing as soon as possible. Beyond COVID-19, new viruses are likely to emerge in the future. As an engineer, I will continue to contribute to the medical field.
Message from Associate Professor Wataru Hijikata

Wataru Hijikata,
Associate Professor,
School of Engineering
Message from Associate Professor Wataru Hijikata
Although my expertise is in mechanical engineering and I'm not a doctor, I find it very satisfying and rewarding working to save people's lives as an engineer. I want young people to know that an engineer's work can save many lives. Especially in recent years, there has been increasing collaboration between medicine and engineering, and the collaboration between medical scientists and engineers is becoming more and more important in the growth and innovation of medicine. In addition, with developed countries in particular experiencing a declining birthrate and aging population, research on medical robots, caregiving robots, and other medical devices is accelerating. I will continue to promote collaboration between medicine and engineering as an engineer and work to create a prosperous society.
Masakazu Sekijima, Associate Professor, School of Computing
My expertise is in in silico drug discovery, using information science and technology such as machine learning and large-scale supercomputer simulations. It currently takes about 300 billion yen and 10 plus years for a pharmaceutical company to launch one new drug. Therefore, in recent years there has been a growing shift to use IT for virtual screening to search for candidate compounds for new drugs.
Since a drug compound and a protein related to a disease are like a key and keyhole, my lab has been performing "docking simulations" using Tokyo Tech's TSUBAME3.0 supercomputer to narrow down candidate compounds. This is to verify by simulation whether or not the keyhole protein and the key candidate compound bind well. For Chagas disease, also known as American trypanosomiasis, we have thus succeeded in obtaining 4 hit compounds, narrowing down from about 5 million candidate compounds to about 180 and verifying them in biochemical experiments.
However, biochemical experiments showed that the narrowed down candidate compounds include many that do not bind well. Therefore, we developed SIEVE-Score, a new tool for evaluating the interaction between amino acids of proteins and candidate compounds using artificial intelligence (AI), aiming to improve the accuracy of virtual screening.
As early as the beginning of January 2020, a Chinese research group published the genome of the novel coronavirus (SARS-CoV-2). From this information, I learned that SARS-CoV-2 and the SARS virus (SARS-CoV) have similar genomic sequences, and I intuitively thought that research on SARS could be applied to COVID-19.
In particular, candidate compounds that block the action of the enzyme main protease, which is essential for virus growth, are known for various viruses. We investigated how these candidate compounds bind to the main protease of SARS-CoV-2 through a molecular dynamics simulation using TSUBAME3.0 supercomputer to trace the movement of molecules. We eventually succeeded in modeling the three-dimensional structure called the "pharmacophore" that represents the interaction between the protein and the candidate compound. Based on this result, we plan to further narrow down the candidate compounds that inhibit the growth of SARS-CoV-2 from the existing drugs by using SIEVE-Score.


Verification of how SARS-CoV-2 main protease and the drug candidate α-ketoamide inhibitor fit pharmacophore models. α-ketoamide is a peptide-like compound and is known to inhibit the main protease activity of viruses. It has been speculated that the main protease of SARS-CoV-2 interacts with α-ketoamide. By searching for compounds that interact in the pharmacophore model as shown here, it may be possible to find therapeutic candidates for SARS-CoV-2.
Ryosuke Yoshino, Nobuaki Yasuo and Masakazu Sekijima
"Identification of key interactions between SARS–CoV–2
main protease and inhibitor drug candidates"
Scientific Reports vol 10, Article number: 12493 (2020)
[10.1038/s41598-020-69337-9]![]()
The lesson I learned from the COVID-19 pandemic is that while we do not know when new pandemics will emerge, we need to quickly develop a platform to deal with them. Genomic sequences and three-dimensional structures of various viruses, as well as candidate compounds that are likely to inhibit their function, can be centrally managed on the platform, and quickly analyzed using simulation tools and machine learning to narrow down candidate compounds and lead to drug discovery.
Message from Associate Professor Masakazu Sekijima

Masakazu Sekijima,
Associate Professor,
School of Computing
Message from Associate Professor Masakazu Sekijima
My expertise is in computer science, and I have been searching through computer simulations for therapeutic agents for infectious diseases caused by protozoan parasites. In recent years, we have been making full use of machine learning and other AI approaches to improve accuracy. I have been focusing on infectious diseases like Chagas' disease and African sleeping sickness, for which no treatments have yet been developed, as they are prevalent in developing countries. But my research is fortunately useful for COVID-19 research. On the other hand, there are many other risks we face, such as floods and earthquakes. My research is powerless against such risks. Therefore, what I want to convey to young people is to contribute to the world based on whatever situation presents itself. If you are serious about your own research, then I believe the day will come when it becomes useful.
The Special Topics component of the Tokyo Tech Website shines a spotlight on recent developments in research and education, achievements of its community members, and special events and news from the Institute.
Past features can be viewed in the Special Topics Gallery.
Published: September 2020